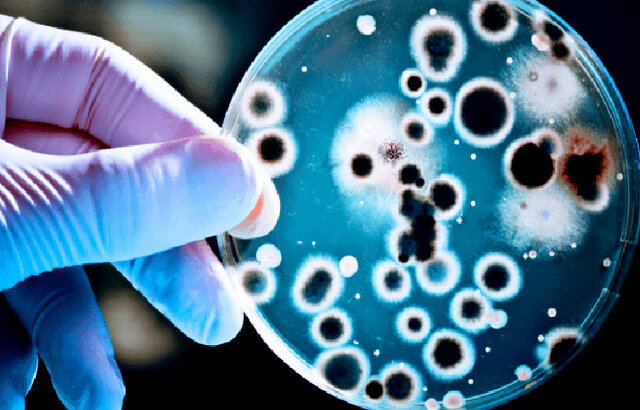
La penicilina

-
 El 12 de diciembre de 1921 Banting y Best descubrieron la insulina, que nació como una posible esperanza de cura. Al año siguiente, Leonard Thompson, un niño de 14 años con diabetes severa, fue el primer paciente al que se le aplicó una inyección de extracto pancreático vacuno.
El 12 de diciembre de 1921 Banting y Best descubrieron la insulina, que nació como una posible esperanza de cura. Al año siguiente, Leonard Thompson, un niño de 14 años con diabetes severa, fue el primer paciente al que se le aplicó una inyección de extracto pancreático vacuno. -
 Hace casi 100 años se llegó a un importante punto de inflexión por lo que se refiere a la esperanza de vida de las personas diabéticas de todo el mundo. Aunque la diabetes se conocía desde la antigüedad, seguía sin existir un tratamiento eficaz. En 1674, el físico Thomas Willis apodó a la diabetes «The Pissing Evil.
Hace casi 100 años se llegó a un importante punto de inflexión por lo que se refiere a la esperanza de vida de las personas diabéticas de todo el mundo. Aunque la diabetes se conocía desde la antigüedad, seguía sin existir un tratamiento eficaz. En 1674, el físico Thomas Willis apodó a la diabetes «The Pissing Evil. -
 Las aptitudes de este aparato eficaz y sencillo han llevado al estetoscopio a mantener su vigencia vinculado a la medicina. Partiendo de un rudimentario ‘cilindro de madera’ de 30 centímetros cuando fue inventado en 1816 por el Doctor francés René Laënnec. Que permitió abandonar la técnica de la auscultación inmediata (posicionar el oído directamente en el cuerpo del paciente).
Las aptitudes de este aparato eficaz y sencillo han llevado al estetoscopio a mantener su vigencia vinculado a la medicina. Partiendo de un rudimentario ‘cilindro de madera’ de 30 centímetros cuando fue inventado en 1816 por el Doctor francés René Laënnec. Que permitió abandonar la técnica de la auscultación inmediata (posicionar el oído directamente en el cuerpo del paciente). -
 La creación del fonendoscopio supuso en la medicina un avance de medio siglo en la exploración y descripción de determinadas enfermedades. Precisó su diferenciación y el diagnóstico de las mismas. Gracias a la invención de Laënec y la publicación de su obra en 1819: “De la auscultación mediada o tratado sobre diagnóstico de enfermedades de los pulmones y el corazón basado principalmente a partir de este nuevo medio de exploración”.
La creación del fonendoscopio supuso en la medicina un avance de medio siglo en la exploración y descripción de determinadas enfermedades. Precisó su diferenciación y el diagnóstico de las mismas. Gracias a la invención de Laënec y la publicación de su obra en 1819: “De la auscultación mediada o tratado sobre diagnóstico de enfermedades de los pulmones y el corazón basado principalmente a partir de este nuevo medio de exploración”. -
 Desde entonces el fonendoscopio ha ido evolucionando paulatinamente hasta derivar en el clásico modelo que ha acompañado a las generaciones actuales en su visita al médico. Un artilugio compuesto por una campana con una sensible membrana adherida. Enlazado con un tubo de goma por el que transcurre el sonido hasta desembocar en dos conductos con sendas olivas que facilitan el acople en los oídos y aíslan de los sonidos externos.
Desde entonces el fonendoscopio ha ido evolucionando paulatinamente hasta derivar en el clásico modelo que ha acompañado a las generaciones actuales en su visita al médico. Un artilugio compuesto por una campana con una sensible membrana adherida. Enlazado con un tubo de goma por el que transcurre el sonido hasta desembocar en dos conductos con sendas olivas que facilitan el acople en los oídos y aíslan de los sonidos externos. -
 La verdadera anestesia nace en el siglo XIX de la mano de los descubrimientos de los gases. Se atribuye a Horace Wells, dentista de Connecticut el primer uso de óxido nitroso para extraer piezas dentarias en 1844. Pero, cuando tuvo que demostrar su sistema en el Hospital General de Massachusetts, el paciente comenzó a gritar y Wells cayó en el descrédito y finalmente se suicidó.
La verdadera anestesia nace en el siglo XIX de la mano de los descubrimientos de los gases. Se atribuye a Horace Wells, dentista de Connecticut el primer uso de óxido nitroso para extraer piezas dentarias en 1844. Pero, cuando tuvo que demostrar su sistema en el Hospital General de Massachusetts, el paciente comenzó a gritar y Wells cayó en el descrédito y finalmente se suicidó. -
 William Morton demostró en 1846 la eficacia del éter como anestésico general, y en 1847 Simpson aplicó el cloroformo en los partos. John Snow, considerado primer especialista en Anestesia, utilizó el cloroformo en el parto de la reina Victoria, que le nombró “sir” en agradecimiento. El halotano, que fue a su vez sustituido por el enfluorano, y hoy en día por el sevofluorano y el desfluorano.
William Morton demostró en 1846 la eficacia del éter como anestésico general, y en 1847 Simpson aplicó el cloroformo en los partos. John Snow, considerado primer especialista en Anestesia, utilizó el cloroformo en el parto de la reina Victoria, que le nombró “sir” en agradecimiento. El halotano, que fue a su vez sustituido por el enfluorano, y hoy en día por el sevofluorano y el desfluorano. -
El 8 de noviembre de 1895 el físico alemán Wilhelm Conrad Roentgen descubrió los rayos X mientras realizaba experimentos con tubos de vacío y un generador eléctrico. Con el hallazgo de este haz de luz capaz de atravesar la materia, nació el diagnóstico médico por imágenes que mejoró considerablemente el ejercicio de la medicina.
-
En marzo de 1896 la prensa colombiana escribe notas emocionadas acerca del nuevo descubrimiento de los rayos X.
-
El 15 de septiembre de 1928, el científico británico Alexander Fleming anuncia el descubrimiento de la penicilina.
El 15 de septiembre de 1928, el científico británico Alexander Fleming anuncia el descubrimiento de la penicilina. -
 Cada una de ellas reacciona contra las bacterias en diferente grado, algunos de los tipos de penicilinas más empleados son: *Ampicilina
Cada una de ellas reacciona contra las bacterias en diferente grado, algunos de los tipos de penicilinas más empleados son: *Ampicilina
*Amoxicilina
*Flucloxacilina
*Fenoximetilpenicilina -
 La penicilina fue uno de los primeros antibióticos que se inventaron y también uno de los que más se utilizaron en todo el mundo. Durante años, gracias a los descubrimientos de su creador Alexander Fleming, los antibióticos a base de penicilina han salvado la vida de millones de personas, razón por la cual esta invención constituye una de las más importantes de la historia.
La penicilina fue uno de los primeros antibióticos que se inventaron y también uno de los que más se utilizaron en todo el mundo. Durante años, gracias a los descubrimientos de su creador Alexander Fleming, los antibióticos a base de penicilina han salvado la vida de millones de personas, razón por la cual esta invención constituye una de las más importantes de la historia. -
 En paralelo, se desarrollaron los agentes intravenosos, descubriéndose los barbitúricos a principios del siglo XX (barbital, fenobarbital), y en 1934 apareció el nuevo barbitúrico tiopental o pentotal sódico, utilizado hasta hace poco, siendo sustituido por el Propofol, que es el agente intravenoso más utilizado en la actualidad.
En paralelo, se desarrollaron los agentes intravenosos, descubriéndose los barbitúricos a principios del siglo XX (barbital, fenobarbital), y en 1934 apareció el nuevo barbitúrico tiopental o pentotal sódico, utilizado hasta hace poco, siendo sustituido por el Propofol, que es el agente intravenoso más utilizado en la actualidad.


